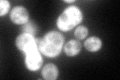
YML100W
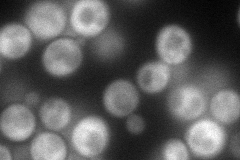
YML100W
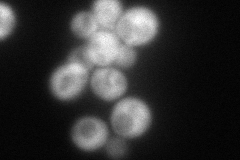
YML100W
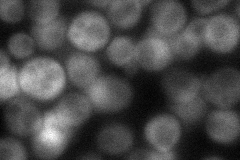
YML100W
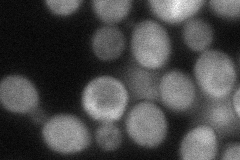
YML100W
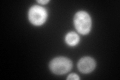
YML100W
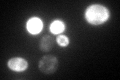
YML100W

View description
Large subunit of trehalose 6-phosphate synthase (Tps1p)/phosphatase (Tps2p) complex, which converts uridine-5'-diphosphoglucose and glucose 6-phosphate to trehalose, homologous to Tps3p and may share function
Localization:
Intensity:
Fold change:
Significance:
-
C’ GFP library in SD
cytosol117.76 -
N' NOP1pr-GFP in SD
cytosol107.931 -
N' TEF2pr-mCherry in SD
cytosol100.075 -
N' NATIVEpr-GFP in SD
cytosol49.7468 -
N' TEF2pr-VC and Cyto-VN in SD
cytosol65.3248 -
C’ GFP library in SD+DTT
cytosol246.992.09Yes -
C’ GFP library in SD+H2O2

cytosol170.31.44Yes -
C’ GFP library in Starvation Media
cytosol252.592.14Yes -
C’ GFP library on the background of Pup2-DaMP

cytosol -
C’ GFP library on the background of CCT mutant

cytosol137.3081.16596No
